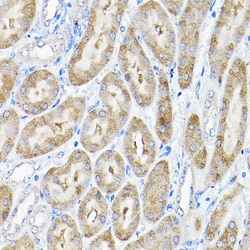

Learn More
Invitrogen™ THUMPD3 Polyclonal Antibody


Rabbit Polyclonal Antibody
Supplier: Invitrogen™ PA587874
Description
Immunogen sequence: MCDIEEATNQ LLDVNLHENQ KSVQVTESDL GSESELLVTI GATVPTGFEQ TAADEVREKL GSSCKISRDR GKIYFVISVE SLAQVHCLRS VDNLFVVVQE FQDYQFKQTK EEVLKDFEDL AGKLPWSNPL KVWKINASFK KKKAKRKKIN QNSSKEKINN GQEVKIDQRN VKKEFTSHAL DSHILDYYEN PAIKEDVSTL IGDDLASCKD ETDESSKEET EPQVLKFRVT CNRAGEKHCF TSNEAARDFG; Positive Samples: LO2, A-549, MCF-7.
THUMPD3 a protein of unknown function. Its domain structure suggests that it is a methylase. It contains a THUMP domain (an RNA-binding domain) and a UPF0020 domain (putative methylase).
Specifications
| THUMPD3 | |
| Polyclonal | |
| Unconjugated | |
| THUMPD3 | |
| AW556087; gene trap ROSA 26 antisense, Philippe Soriano; Gt(ROSA)26asSor; Gtrosa26as; GtROSA26asSor; RGD1560852; thum3; THUMP domain containing 3; THUMP domain-containing protein 3; THUMPD3 | |
| Rabbit | |
| Affinity Chromatography | |
| RUO | |
| 14911, 25917, 500288 | |
| -20°C, Avoid Freeze/Thaw Cycles | |
| Liquid |
| ELISA, Immunohistochemistry (Paraffin), Western Blot | |
| 3.95 mg/mL | |
| PBS with 50% glycerol and 0.02% sodium azide; pH 7.3 | |
| P97770, Q9BV44 | |
| THUMPD3 | |
| Recombinant fusion protein containing a sequence corresponding to amino acids 1-250 of human THUMPD3 (NP_0562682). | |
| 100 μL | |
| Primary | |
| Human, Mouse, Rat | |
| Antibody | |
| IgG |
Safety and Handling
Your input is important to us. Please complete this form to provide feedback related to the content on this product.